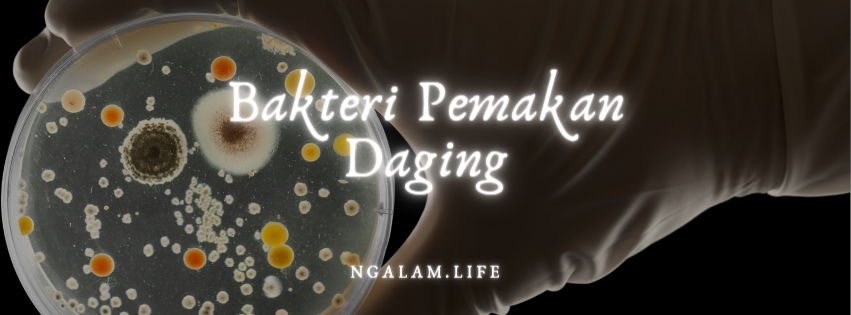

Apakah anda sudah pernah mendengar bakteri pemakan daging? Mungkin di Indonesia bakteri ini terbilang lagka, namun bukan berarti kita tidak perlu mengetahui tentang gejala infeksi bakteri pemakan daging ini. Oleh karena itu, simaklah artikel kita kali ini, artikel kali ini akan membahas tentang bahaya dari bakteri pemakan daging.
BAKTERI APA INI?
Bakteri pemakan daging merupakan bakteri yang dapat memicu infeksi yang cukup berbahaya bagi luka. Luka yang awalnya mungkin terlihat ringan, seperti misalnya luka gigitan ataupun sayatan. Apabila tidak segera diobati, maka bakteri pemakan daging ini dapat menyebabkan infeski yang nantinya akan mengakibatkan kecacatan, diamputasi, hingga bahkan kematian. Bakteri ini, dapat merusak jaringan tubuh dengan menyebarkan racun ke bagian kulit, bagian lemak yang ada dibawah kulit, hingga ke bagian jaringan tipis yang membukus bagian organ tubuh ataupun otot.
Bakteri ini masuk melalui luka yang ada pada tubuh kita. Luka yang terinfeksi bakteri pemakan daging pada umumnya lebih cepat memburuk dan membusuk dibandingkan dengan luka pada umumnya. Jika hal ini tidak diobati secepatnya, akan menimbulkan kondisi yang fatal pada tubuh, hingga membuat tubuh yang terinfeksi harus diamputasi. Tidak hanya itu, infeksi bakteri pemakan daging ini juga dapat menimbulkan kematian pada penderitanya.
PENYEBAB INFEKSI BAKTERI PEMAKAN DAGING
Necrotizing merupakan kondisi dimana jaringan kulit pada bagian tubuh mati dan membusuk sehingga diharuskan melakukan pengangkatan bagian jaringan yang mati dan membusuk. Kondisi langka ini diakibatkan oleh infeksi bakteri pemakan daging. Dimana bakteri tersebut dapat masuk melalui celah yang terbuat dari luka pada bagian tubuh. Berikut beberapa jenis bakteri pemakan daging:
- Aeromonas Hydrophila
- Bacteroides, Prevotella, Clostridium, dan Klebsiella
- Streptococus Grup A
- Escherichia Coli (E. Coli)
- Staphylococcud Aureus
Infeksi bakteri pemakan daging ini tergolong kedalam infeksi yang berbahaya. Namun, infeksi bakteri pemakan daging ini sangat jarang terjadi. Berikut beberapa faktor yang dapat meningkatkan persentase terkena infeksi bakteri pemakan daging, yaitu antara lain:
- Penyakit Kardiovaskular Atau Disebut Penyakit Jantung dan Pembuluh Darah Perifer
- Diabetes Melitus
- Kanker
- TBC Atau Tuberkulosis
- Kerusakan Pada Organ Contohnya Sirosis Pada Hati dan Gagal Ginjal
- Efek Samping Dari Penggunaan Obat-obatan Contohnya Kemoterapi Atau Kortikosteroid Jangka Panjang
- Lemahnya Daya Tahan Tubuh Contohnya Malnutrisi Atau Bahkan Terinfeksi HIV
- Kecanduan Obat-obatan Terlarang Dalam Bentuk Suntik Atau Alkohol Yang Berlebihan
APA SAJA GEJALA INFEKSI BAKTERI PEMAKAN DAGING?
Adapun gejala infeksi bakteri pemakan daging ini sendiri dibagi menjadi 3 tahap gejala, yaitu sebagai berikut:
- Gejala Awal
Gejala awal infeksi bakteri pemakan daging ini biasanya timbul dalam kurun waktu 24 jam dan gejala ini ditandai dengan demam yang di ikuti rasa nyeri yang berat pada bagian tubuh yang terinfeksi oleh bakteri pemakan daging. Rasa sakit yang dirasakan oleh penderita infeksi biasanya melebihi dari rasa sakit luka normal yang dialami.
- Gejala Lanjutan
Gejala lanjutan infeksi bakteri pemakan daging ini biasanya terjadi dalam kurun waktu kurang lebih 3 hingga 4 hari setelah bakteri ini berhasil masuk kedalam tubuh melalui cela yang ada pada luka. Adapun gejala yang ditimbulkan ialah berupa mual hingga muntah, dan bahkan diare.
- Gejala Kritis
Gejala kritis innfeksi bakteri pemakan daging ini biasanya muncul dalam kurun waktu 4 hingga 5 hari setelah terinfeksi. Adapun gejala yang biasanya timbul ialah penurunan tekanan darah yang drastis, dan jika tidak diobati segera, penderita bisa saja mengalami koma hingga meninggal dunia.
Itulah hal-hal yang perlu anda ketahui terkait infeksi bakteri pemakan daging. Mungkin terlihat sepele namun sangat berbahaya bagi tubuh jika sudah terinfeksi bakteri pemakan daging ini. Oleh karena itu, selalu waspada akan infeksi bakteri pemakan daging. Jangan lupa untuk tetap berhati-hati agar tidak terkena luka.